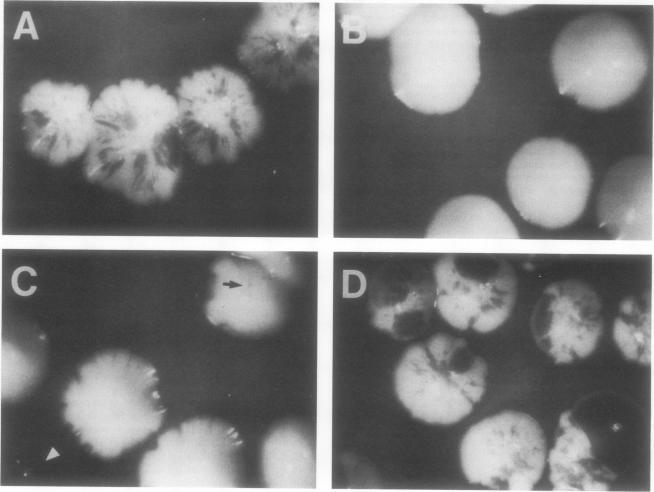

一项合成致死筛选鉴定出了SLK1,这是一种与酵母细胞形态发生和细胞生长有关的新型蛋白激酶同源物。
A synthetic lethal screen identifies SLK1, a novel protein kinase homolog implicated in yeast cell morphogenesis and cell growth.
作者信息
Costigan C, Gehrung S, Snyder M
机构信息
Department of Biology, Yale University, New Haven, Connecticut 06511.
出版信息
Mol Cell Biol. 1992 Mar;12(3):1162-78. doi: 10.1128/mcb.12.3.1162-1178.1992.
The Saccharomyces cerevisiae SPA2 protein localizes at sites involved in polarized cell growth in budding cells and mating cells. spa2 mutants have defects in projection formation during mating but are healthy during vegetative growth. A synthetic lethal screen was devised to identify mutants that require the SPA2 gene for vegetative growth. One mutant, called slk-1 (for synthetic lethal kinase), has been characterized extensively. The SLK1 gene has been cloned, and sequence analysis predicts that the SLK1 protein is 1,478 amino acid residues in length. Approximately 300 amino acids at the carboxy terminus exhibit sequence similarity with the catalytic domains of protein kinases. Disruption mutations have been constructed in the SLK1 gene. slk1 null mutants cannot grow at 37 degrees C, but many cells can grow at 30, 24, and 17 degrees C. Dead slk1 mutant cells usually have aberrant cell morphologies, and many cells are very small, approximately one-half the diameter of wild-type cells. Surviving slk1 cells also exhibit morphogenic defects; these cells are impaired in their ability to form projections upon exposure to mating pheromones. During vegetative growth, a higher fraction of slk1 cells are unbudded compared with wild-type cells, and under nutrient limiting conditions, slk1 cells exhibit defects in cell cycle arrest. The different slk1 mutant defects are partially rescued by an extra copy of the SSD1/SRK1 gene. SSD1/SRK1 has been independently isolated as a suppressor of mutations in genes involved in growth control, sit4, pde2, bcy1, and ins1 (A. Sutton, D. Immanuel, and K.T. Arnat, Mol. Cell. Biol. 11:2133-2148, 1991; R.B. Wilson, A.A. Brenner, T.B. White, M.J. Engler, J.P. Gaughran, and K. Tatchell, Mol. Cell. Biol. 11:3369-3373, 1991). These data suggest that SLK1 plays a role in both cell morphogenesis and the control of cell growth. We speculate that SLK1 may be a regulatory link for these two cellular processes.
酿酒酵母的SPA2蛋白定位于出芽细胞和交配细胞中参与极性细胞生长的位点。spa2突变体在交配过程中形成突起存在缺陷,但在营养生长期间是健康的。设计了一个合成致死筛选来鉴定在营养生长中需要SPA2基因的突变体。一个名为slk-1(合成致死激酶)的突变体已被广泛研究。SLK1基因已被克隆,序列分析预测SLK1蛋白长度为1478个氨基酸残基。羧基末端约300个氨基酸与蛋白激酶的催化结构域表现出序列相似性。已在SLK1基因中构建了破坏突变。slk1缺失突变体在37℃下不能生长,但许多细胞可以在30、24和17℃下生长。死亡的slk1突变体细胞通常具有异常的细胞形态,许多细胞非常小,大约是野生型细胞直径的一半。存活的slk1细胞也表现出形态发生缺陷;这些细胞在暴露于交配信息素时形成突起的能力受损。在营养生长期间,与野生型细胞相比,更高比例的slk1细胞未出芽,并且在营养限制条件下,slk1细胞在细胞周期停滞方面存在缺陷。SSD1/SRK1基因的额外拷贝部分挽救了不同的slk1突变体缺陷。SSD1/SRK1已被独立分离为参与生长控制的基因(sit4、pde2、bcy1和ins1)突变的抑制子(A. Sutton、D. Immanuel和K.T. Arnat,《分子细胞生物学》11:2133 - 2148,1991;R.B. Wilson、A.A. Brenner、T.B. White、M.J. Engler、J.P. Gaughran和K. Tatchell,《分子细胞生物学》11:3369 - 3373,1991)。这些数据表明SLK1在细胞形态发生和细胞生长控制中都起作用。我们推测SLK1可能是这两个细胞过程的调节纽带。